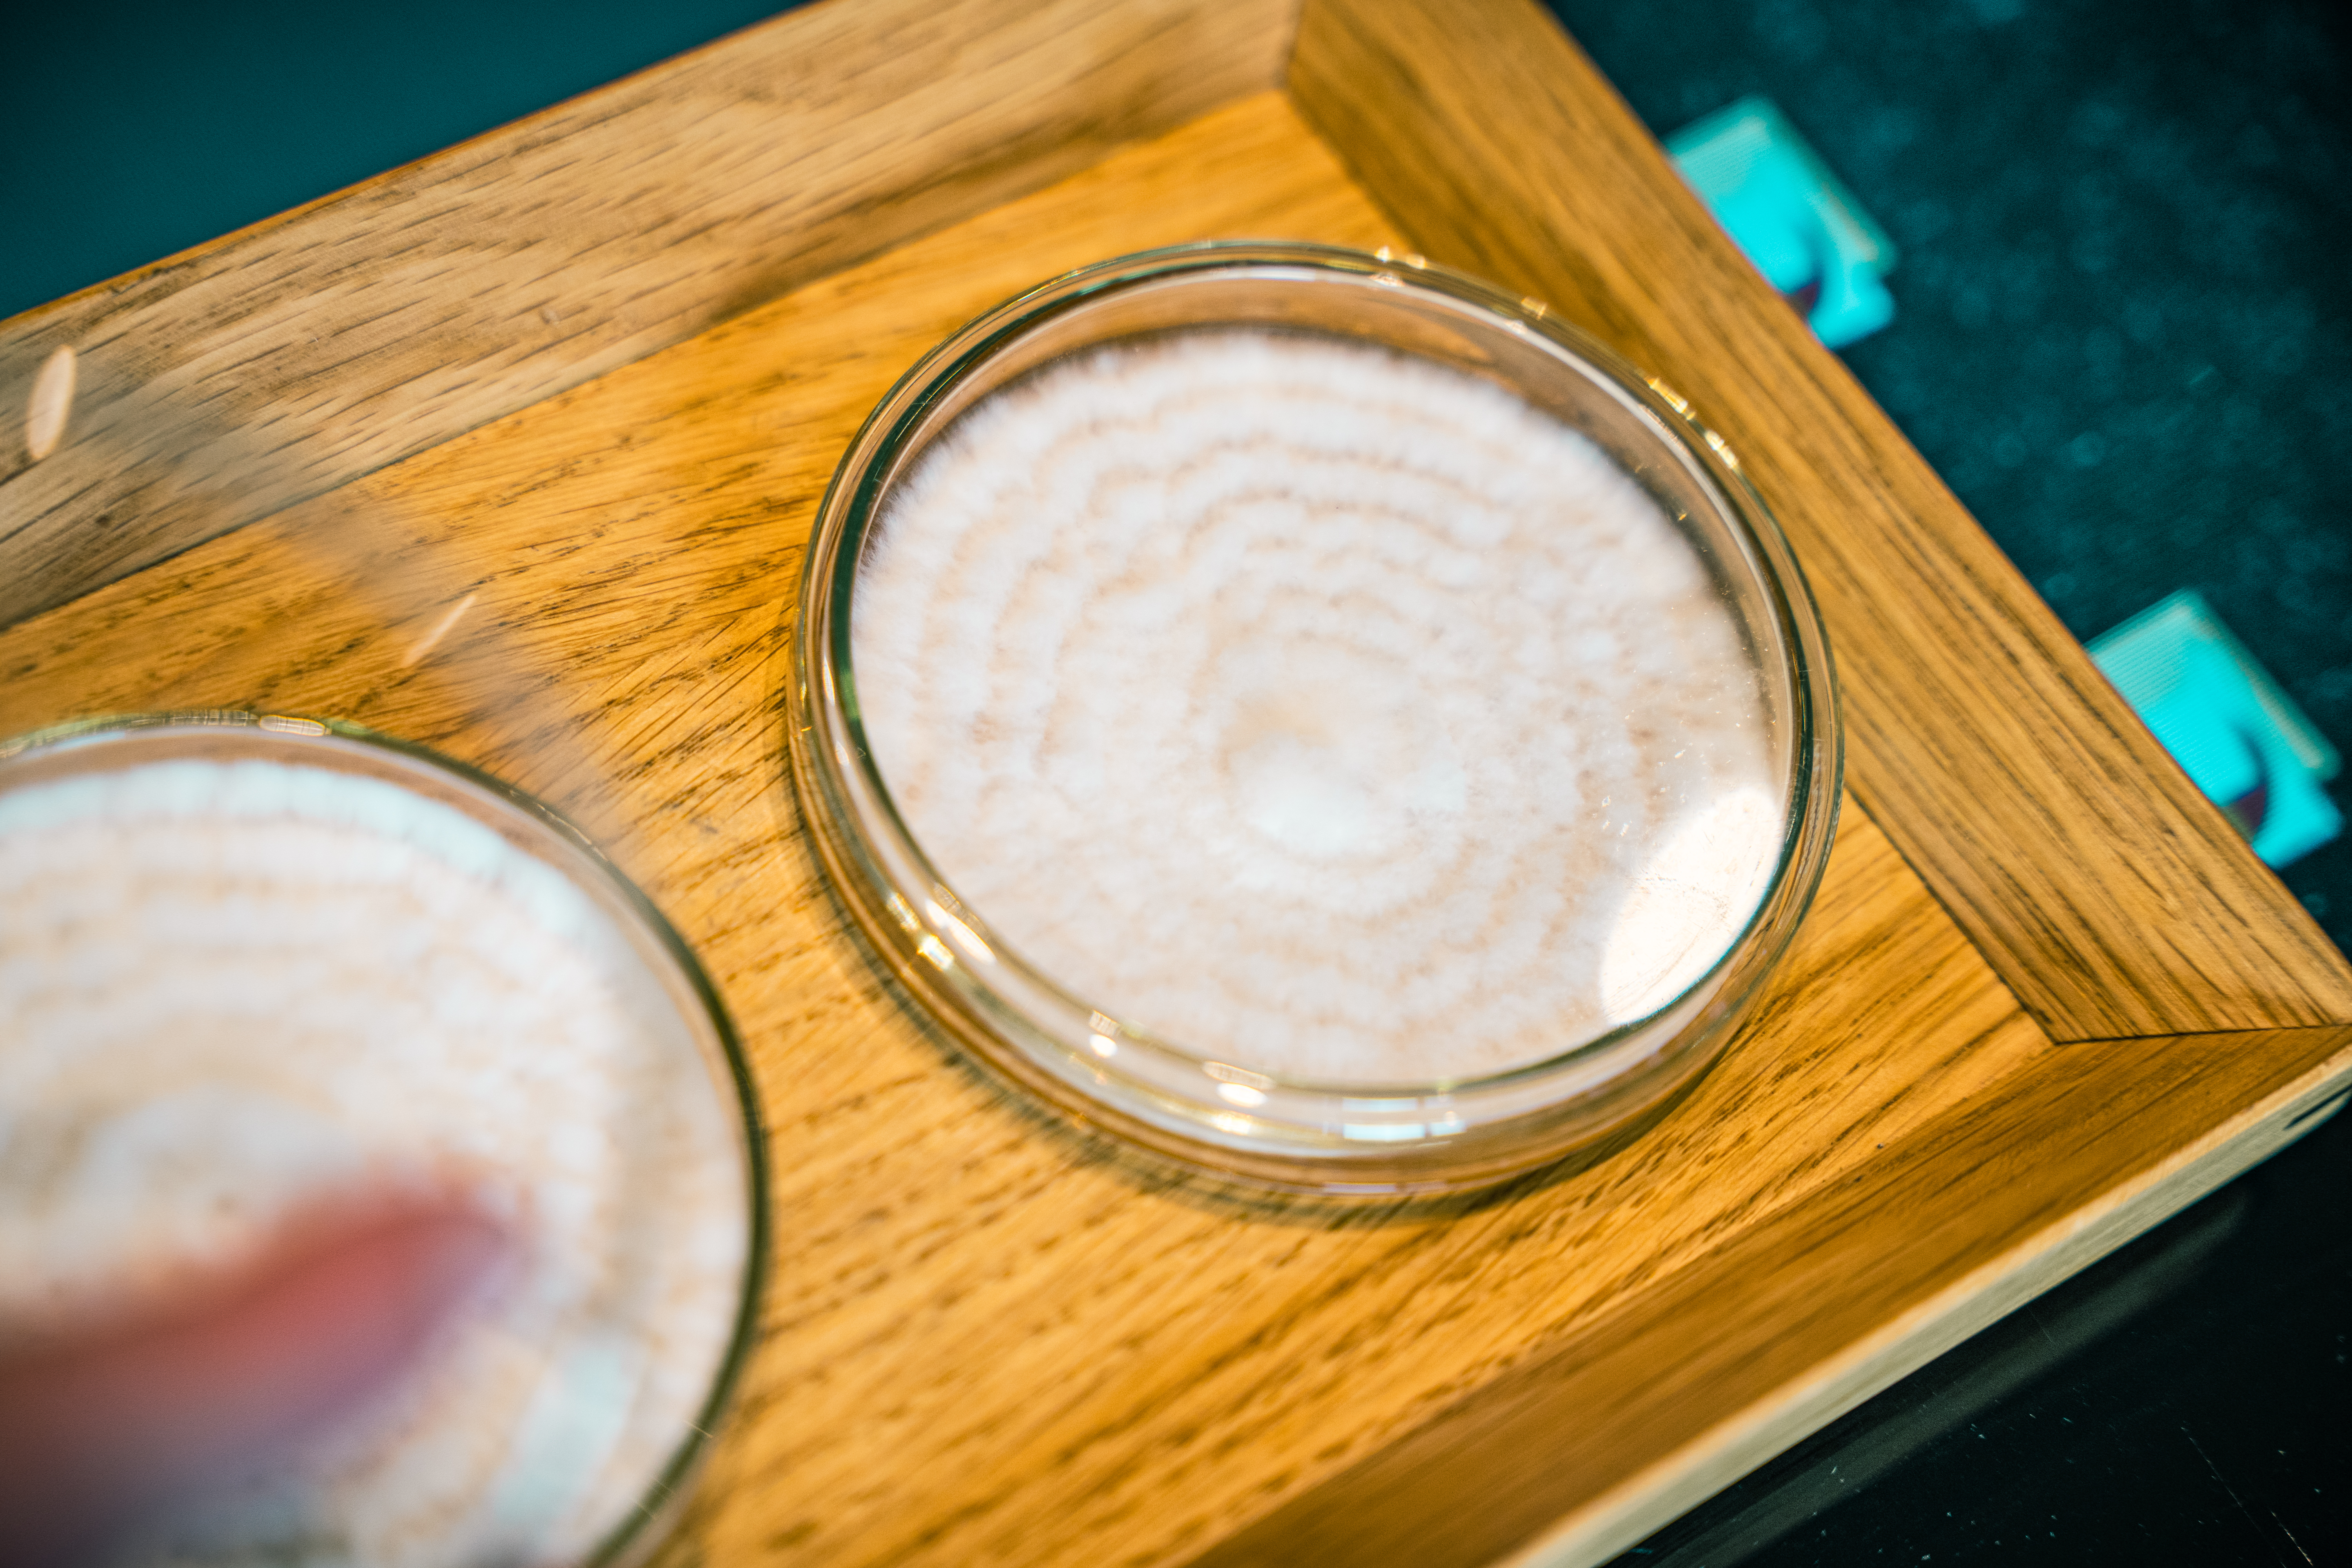

Ons dieet wordt steeds plantaardiger. Hierdoor verschuiven paddenstoelen van de rand, naar het midden van ons bord. Paddenstoelen zijn immers rijk aan umami, duurzaam, smaakvol en worden in veel meer producten en gerechten verwerkt dan je zou denken. In deze serie verkennen we het brede scala aan kenmerken van schimmels. Deel 2: schimmels als smaakmakers.
Dat paddenstoelen door velen zo lekker worden gevonden, heeft alles te maken met het hoge gehalte aan umami. Ook wel gezien als ‘de vijfde smaak’ na bitter, zoet, zout en zuur. In het Japans betekent umami ‘heerlijk’. Het wordt omschreven als een hartige, kruidige, rijke of vlezige smaaksensatie. Voor wetenschappers duidt umami op een hoog gehalte aan glutamaat, een aminozuur en bouwsteen van eiwitten. Voor koks en fijnproevers is het een bevredigend gevoel van diepe smaak, waarbij hartige en volle smaken in evenwicht zijn met het aroma en mondgevoel van een product of gerecht. Producten als champignons, tomaten, Parmezaanse kaas en groene thee zijn rijk aan umami.
Schimmel als smaakmaker
Hoewel de populariteit van bekende paddenstoelen als shiitake en oesterzwam toeneemt, zitten er nog veel meer ‘paddenstoelen’ in eten dan je misschien beseft. Brood, bier, chocolade en wijn? Ze hebben gemeen dat ze allemaal gemaakt zijn door middel van fermentatie met gisten; eencellige schimmels. Louis Pasteur bracht halverwege de vorige eeuw de rol van gisten in ons eten aan het licht. Hij ontdekte dat door middel van fermentatie gisten kooldioxide en alcohol generen. Eigenschappen die nodig zijn voor de productie van bier, wijn en brood. Saccharomyces cerevisiae is de meest populaire vertegenwoordiger van gisten die helpen met het maken van eten. Er zijn echter nog vele andere, minder bekende gisten die worden gebruikt. In sommige gevallen zijn gisten zelfs de bron van smaak, kleur en vitaminen. Een voorbeeld is Penicillium roqueforti, die zorgt voor de kenmerkende smaak in de blauwe kaas Roquefort.
Fermentatie met koji
Het zijn niet alleen gisten die producten smakelijk maken. Ook andere schimmels zijn populair. Zo wordt Aspergillus Oryzae gebruikt om koji te maken met rijst. Koji wordt al eeuwenlang in de Japanse keuken gebruikt om producten als sojasaus, miso, mirin en sake te maken. Tegenwoordig is het gebruik van koji ook doorgedrongen tot de Westerse fine dining scene. De Amerikaanse chefs Jeremy Umansky en Rich Shih zijn toonaangevend in de culinaire kracht van dit ingrediënt. In hun boek Koji Alchemy geven zij een uitgebreide uitleg over het moderne gebruik van koji, om bijvoorbeeld vleeswaren, kaas en groenten snel te laten rijpen. Ook sommige toprestaurants openen hun eigen laboratoria, waarvolop wordt geëxperimenteerd met het gebruik van koji en andere schimmels, vooral bij het creëren van smaakvolle plantaardige gerechten.
Lees hier ook het eerste artikel uit deze serie: De fantastische functies van fungi
Restaurant Alchemist** in Kopenhagen gaat zelfs een stap verder. In hun testkeuken creëerden ze een gerecht waarin mycelium - een netwerk van schimmeldraden - niet als ingrediënt wordt gebruikt, maar juist de ster van de show is. Voor het gerecht wordt een gel van paddenstoelenbouillon geënt met mycelium van oesterzwammen en geserveerd in een petrischaaltje. "Wat extra bijzonder is, is dat het gerecht niet wordt gekookt, maar in onze keuken wordt gekweekt", zegt Diego Prado, Head of Research bij Alchemist Explore.
Noma Projects
Bij restaurant Noma*** in Kopenhagen - dat vier keer uitgeroepen werd tot 's werelds beste restaurant - is het gebruik van ferementatie ook erg populair. Voor veel van hun gefermenteerde producten wordt koji gebruikt. Tijdens COVID-19 opende het wereldberoemde restaurant Noma Projects, een onderzoeksruimte waar het team ook plantaardige conserven ontwikkelt om mensen thuis te helpen en te inspireren om smaakvolle plantaardige maaltijden te maken. Het eerste product dat ze op de markt brachten was een garum van gerookte paddenstoelen. Garum is oorspronkelijk een gefermenteerde vissaus, afkomstig uit uit het Middellandse Zeegebied. Waar traditionele recepten vertrouwen op de natuurlijk voorkomende enzymen in de darmen van een vis, die op hun beurt de vis af te breken tot een saus, wordt er bij Noma Projects koji gebruikt om een soortgelijk proces na te bootsen.
Door koji te in te zetten is het mogelijk om met een breder scala aan ingrediënten een garum te maken. "Door koji te gebruiken kunnen we ook garum maken van groenten of zelfs schimmels. Voor onze gerookte paddenstoelengarum gebruiken we biologische paddenstoelen met zout en koji, deze laten we zes tot acht weken trekken. De saus heeft daardoor aardse, fruitige, complexe smaken met veel umami,” zo stelt de organisatie op hun website.
Lees hier ook het eerste artikel uit deze serie: De fantastische functies van fungi
 Door
Door 



























